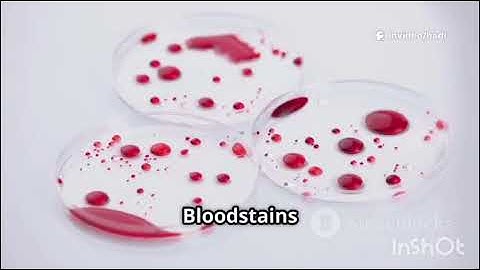
How Forensics Solve Crimes 👁️

⬇ DOWNLOAD NOW
Kalau muncul iklan pop-up, tutup lalu klik tombol kembali
Download lagu Forensics by Val McDermid: 25 Minute Summary secara gratis hanya untuk keperluan promosi. Dukung artis favorit kamu dengan membeli musik original di iTunes atau platform resmi lainnya.
 Forensics: What Bugs, Burns, Prints, DNA, and More Tell Us About Crime
Forensics: What Bugs, Burns, Prints, DNA, and More Tell Us About Crime
 "Forensics" by Val McDermid
"Forensics" by Val McDermid
 Forensics: What Bugs, Burns, Prints, DNA, and More Tell Us about Crime by Val McDermid
Forensics: What Bugs, Burns, Prints, DNA, and More Tell Us about Crime by Val McDermid
 Audiobook Summary: Forensics (English) Val McDermid
Audiobook Summary: Forensics (English) Val McDermid
How Forensics Solve Crimes 👁️
How Forensics Solve Crimes 👁️
 Val McDermid 'Forensics: The Anatomy of Crime'
Val McDermid 'Forensics: The Anatomy of Crime'
 Val McDermid: The Magic of Forensics
Val McDermid: The Magic of Forensics
 Val McDermid Q&A: Is it possible that forensics can't explain a person’s death?
Val McDermid Q&A: Is it possible that forensics can't explain a person’s death?